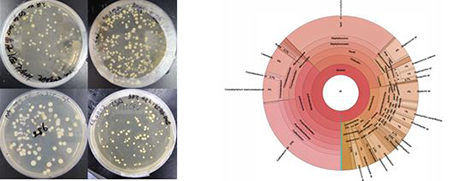

입력 2026.01.07 16:13
- 학부연구팀, 출입문 손잡이 주목한 연구 결과 '대한환경공학회지'에 게재
- 일상 접촉 환경에 대한 주목과 위생 관리의 중요성을 과학적으로 제시

건국대학교 공과대학 생물공학과 학부생 연구팀이 교내 주요 시설의 출입문 손잡이를 대상으로 미생물 오염도를 분석한 연구 성과를 발표해 주목받고 있다. 농촌진흥청의 지원을 받아 수행된 이번 연구는 학술적 우수성을 인정받아 KCI 등재 학술지인 ‘대한환경공학회지’ 최신호에 게재됐다.
연구팀은 학생과 교직원의 이용 빈도가 높은 교내 건물 출입문 손잡이를 대상으로 시료를 채취해 미생물 분포 양상을 분석했다. 그 결과, 출입문 손잡이 표면에서는 포도상구균, 연쇄상구균 및 각종 피부 병원성 미생물과 폐렴 유발 미생물이 확인됐으며, 미생물 수는 1cm²당 평균 346CFU(집락형성단위)로 나타났다. 이는 일반적으로 위생 관리가 필요하다고 평가되는 고수준으로 오염된 변기 시트의 평균 미생물 수(1cm²당 약 300CFU)를 능가하는 수치다.
이번 연구는 단순한 미생물 검출에 그치지 않고, 일상 공간에서의 접촉 오염 가능성과 위생 관리 인식 개선의 필요성을 실증적으로 보여줬다는 점에서 의미가 있다. 연구팀은 분석 결과를 바탕으로 다중 이용 시설에 대한 정기적인 소독과 관리 강화, 자동문이나 풋 페달식 개폐 장치로 대표되는 비접촉식 출입 시스템 도입 등 위생 환경 개선 방안의 필요성을 함께 제시했다.
특히 이번 연구는 학부생들이 연구 주제 설정부터 실험 설계, 시료 분석, 결과 해석까지 전 과정을 주도적으로 수행해 도출한 성과라는 점에서도 주목된다. 이번 연구는 지도교수의 지도 아래 체계적인 수행 과정을 거쳐 학술지 게재로 이어지며, 건국대 학부생 연구의 교육적·학문적 가능성을 입증했다.
건국대 생물공학과는 실험과 연구 중심의 교육을 통해 학부 과정부터 실제 연구 현장에서 문제를 발견하고 과학적으로 검증하는 경험을 쌓을 수 있도록 지원하고 있다. 전공 교육과 연계한 연구 활동을 통해 학생들의 연구 역량과 학문적 성장을 지속적으로 도모하고 있다.
주요 세균 군집의 비율과 구성을 시각적으로 확인할 수 있도록 한 원형 그래프(오른쪽)
이번 연구 성과는 일상 생활 공간의 위생 관리에 대한 사회적 관심을 환기하는 동시에, 학부생 연구가 교육을 넘어 학문적 성과로 이어질 수 있음을 보여주는 사례로 평가된다. 건국대학교는 앞으로도 학부생 연구 참여 기회를 확대하며 연구 기반 교육을 지속적으로 강화해 나갈 계획이다.